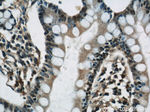
RCC1 Antibody in Immunohistochemistry (Paraffin) (IHC (P))

Search
Proteintech
RCC1 Polyclonal Antibody
{{$productOrderCtrl.translations['antibody.pdp.commerceCard.promotion.promotions']}}
{{$productOrderCtrl.translations['antibody.pdp.commerceCard.promotion.viewpromo']}}
{{$productOrderCtrl.translations['antibody.pdp.commerceCard.promotion.promocode']}}: {{promo.promoCode}} {{promo.promoTitle}} {{promo.promoDescription}}. {{$productOrderCtrl.translations['antibody.pdp.commerceCard.promotion.learnmore']}}
产品信息
22335-1-AP
种属反应
宿主/亚型
分类
类型
抗原
偶联物
形式
浓度
规格
纯化类型
保存液
内含物
保存条件
运输条件
产品详细信息
This antibody is a rabbit polyclonal antibody raised against full length RCC1 of human origin.
Immunogen sequence: MSPKRIAKR RSPPADAIPK SKKVKVSHRS HSTEPGLVLT LGQGDVGQLG LGENVMERKK PALVSIPEDV VQAEAGGMHT VCLSKSGQVY SFGCNDEGAL GRDTSVEGSE MVPGKVELQE KVVQVSAGDS HTAALTDDGR VFLWGSFRDN NGVIGLLEPM KKSMVPVQVQ LDVPVVKVAS GNDHLVMLTA DGDLYTLGCG EQGQLGRVPE LFANRGGRQG LERLLVPKCV MLKSRGSRGH VRFQDAFCGA YFTFAISHEG HVYGFGLSNY HQLGTPGTES CFIPQNLTSF KNSTKSWVGF SGGQHHTVCM DSEGKAYSLG RAEYGRLGLG EGAEEKSIPT LISRLPAVSS VACGASVGYA VTKDGRVFAW GMGTNYQLGT GQDEDAWSPV EMMGKQLENR VVLSVSSGGQ HTVLLVKDKE QS (1-421 aa encoded by BC010067)
靶标信息
Guanine-nucleotide releasing factor that promotes the exchange of Ran-bound GDP by GTP. Involved in the regulation of onset of chromosome condensation in the S phase. Binds both to the nucleosomes and double-stranded DNA. RCC1-Ran complex (together with other proteins) acts as a component of a signal transmission pathway that detects unreplicated DNA. Plays a key role in nucleo-cytoplasmic transport, mitosis and nuclear-envelope assembly.
仅用于科研。不用于诊断过程。未经明确授权不得转售。
生物信息学
蛋白别名: Cell cycle regulatory protein; CHC1; Chromosome condensation protein 1; guanine nucleotide-releasing protein; RAN guanine nucleotide exchange factor; Regulator of chromosome condensation; unnamed protein product
基因别名: 4931417M11Rik; AI326872; CHC1; RCC1; RCC1-I
UniProt ID: (Human) P18754, (Mouse) Q8VE37
Entrez Gene ID: (Human) 1104, (Mouse) 100088, (Rat) 682908